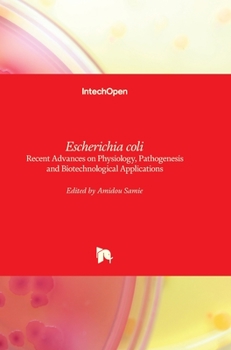
Hardcover Escherichia coli: Recent Advances on Physiology, Pathogenesis and Biotechnological Applications Book

Escherichia coli: Recent Advances on Physiology, Pathogenesis and Biotechnological Applications
No Synopsis Available.
Format:Hardcover
Language:English
ISBN:9535133292
ISBN13:9789535133292
Release Date:July 2017
Publisher:Intechopen
Length:434 Pages
Weight:1.95 lbs.
Dimensions:0.9" x 6.7" x 9.6"
Customer Reviews
0 rating